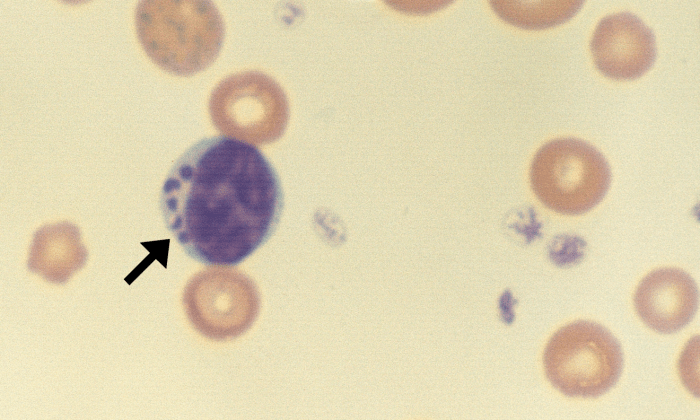
Gran Lymphocytes 4 (Bovine 4) ARROWS

Granular Lymphocytes

Morphology: lymphocytes with pink or red cytoplasmic granules. Granular lymphocytes are either cytotoxic T-cells or natural killer cells.
Look alike: granulocytes (eosinophils, basophils)
Clinical relevance: present in low numbers in healthy animals (1 – 10% of lymphocytes). Most frequently observed in cattle. Increased granular lymphocytes may occur with certain reactive conditions (Ehrlichia canis infection and chronic renal disease in dogs) or with large granular lymphocytic leukemia (LGL).

1 Comment »